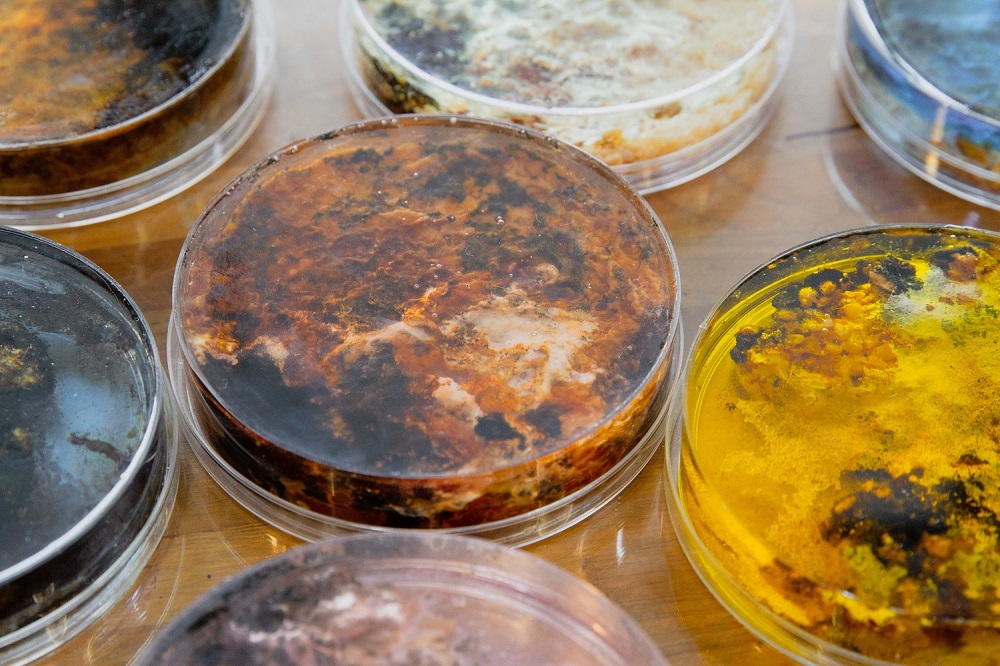

「『學習』要如何面向真實的生活呢?」以此作為核心的命題,本展經由重新梳理新美館於籌備期間(2019-2021)所策劃共41組的館校合作計畫,提出一種萌生自美術老師、藝術家以及學生之間特殊的「三角關係」。
在這種特殊的關係中,學生、藝術家以及學校老師既是在一起學習,也是在共同創作。教與學因而不只是知識的傳遞,在藝術課程中也創造著共享的世界。這不只考驗著不同角色在碰撞中,如何將抽象的知識或經驗轉化,來達成有溫度的溝通與協作。過程中對於建立共感的努力,更讓三者回歸到所處的此時此地,專注於聆聽、對話與覺察,進而得以向著一種更有意識的生活,和更有生活感的學習靠近。
伴隨著一連串的相遇與磨合,為期三年的館校計畫不只在人與人的連結之中,編織起獨特的新關係,也在美術館與校園之間,逐漸凝聚出一種透過藝術來實現的館校學習共同體。
展覽中,透過來自學生、藝術家及美術老師的經驗分享,以及10組涵蓋不同年級的教案成果展示,本展呈現學習歷程的多元風景,並透過經驗及方法的分享,點燃更多對於藝術與學習的嘗試。
展區介紹

「單元一:在遇見你們之前」
邀請來訪的觀眾一同思索,在當代的特殊處境中,美術老師、藝術家和學生各自正面臨著什麼挑戰呢?

「單元二:新三角的誕生」
藉由學生、藝術家及美術老師分享實際參與館校計畫的經驗,為本展道出「三角關係」究竟是如何誕生的呢?

「單元三:給我一個三角關係,我可以______!」
透過十組教案的歷程及成果展示,逐步展開在「三角關係」中關於自我、科技及生態三大面向的學習。

「單元四:未來的形狀」
回顧歷年成果專輯與紀錄影片,並邀請各年齡層的觀眾一起加入「用想像力寫生」的接力創作,以最簡單的圓形貼紙勾勒更多變的未來形狀。
推廣活動
本展設有2場公開講座及3場教師工作坊,歡迎至下方連結報名參加。
講座

講座一:「藝術教育的跨界突破:當陌生的『當代藝術』進入教學現場」
活動時間:2023/12/2 (六) 14:00 - 16:00
主持人:策展人 孫以臻
與談人:藝術家 雜草稍慢、藝術家 許雁婷
內容簡介:結合當代藝術入課的教案往往挑戰著學科的界線,本講座邀請參與計畫的藝術家,探討非典型的藝術進入學校課堂所開啟的對話與挑戰,並共同思索藝術家與藝術教育的協作在未來該如何繼續開展。

講座二:「藝術教育的跨界突破:當設計師進入教學現場」
活動時間:2023/12/9 (六) 10:00 - 12:00
主持人:藝術家 張允菡
與談人:設計師 楊水源、拾拾造物設計師 吳柏翰
內容簡介:藝術和設計有什麼不同,為什麼我們要在學校學設計?設計教育可以帶給學生什麼樣的體驗和挑戰?本講座邀請參與計畫的設計師分享各自完成的教案,並一同聊聊多重身份的他們,如何在藝術家、設計師與教學者的轉換中,持續保持創作與教學的活力。
教案體驗工作坊 (活動對象:教師)
新美館的「館校計畫」歷經三年與藝術家和學校教師的合作,開發了超過40組的藝術教案。此系列工作坊邀請曾參與計畫的藝術家和教師們聊聊教案設計祕辛、分享他們在教學現場如何與學生互動,並且在工作坊中帶領大家實際操作教案,一同探索當代藝術教育的多元可能。
工作坊一:誰來晚餐?
活動時間:2023/12/9 (六) 14:00 - 16:30
講師:青山國中教師 張晨昕、陳美如、張益明

工作坊二:編織生活的質地合流
活動時間:2023/12/16 (六) 14:00 - 16:30
講師:藝術家 織女彤彤

工作坊三:變形魔鏡
活動時間:2023/12/23 (六) 14:00 - 16:30
講師:民安國小教師 蔡宗翰
策展人:孫以臻
主辦單位:新北市美術館
執行單位:害喜影音綜藝有限公司